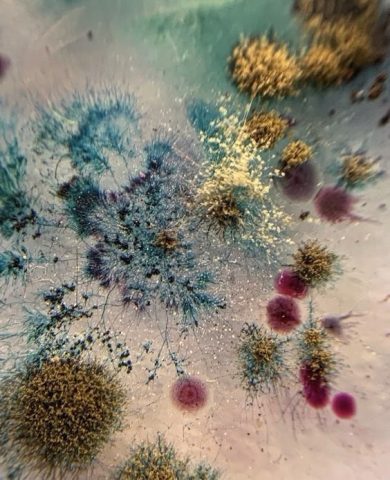

„Din bube, mucegaiuri şi noroi
Iscat-am frumuseţi şi preţuri noi.” Tudor Arghezi
Când locuiam la părinți doream liniște sǎ citesc și să-mi scriu ideile, iar la noi acasǎ era ca într-un muşuroi de furnici, numai mediul ideal concentrării nu era. Am revenit la Sibiu și unde locuiesc urlǎ liniștea prin pereți, aşa cǎ îmi iau laptopul în brațe și merg acasǎ, la mama, sǎ scriu în bucǎtǎrie, sǎ mai trǎiesc forfota plinǎ de inspirație pe care o aveam când eram tânără speranță. Simt că în miezul casei unde am crescut surprind mai acurat realități ce în liniștea-mi sterilă rămân camuflate.
Poate sună bizar, dar nu eu aleg temele despre care scriu, ci ele mă aleg pe mine: mă pomenesc că adorm sau mă trezesc cu o întrebare care până mai ieri nu exista în grila de preocupări și, precum un balon uriaș, se umflă în mintea mea, ocupă tot mai mult spațiu și resurse cognitive. Spargerea balonului înseamnă găsirea unor răspunsuri parțial satisfăcătoare.
Așa am ajuns să filozofez despre durerea care doar doare și durerea care metamorfozează.
Condiția umană este, indubitabil, supusă durerii, indiferent de locul în care te-ai născut, frumusețe, inteligență sau bogăție – te afli, fără acordul explicit, într-o cursă contra cronomentru în care experiențele vieții, boala, îmbătrânirea și moartea te fac să pierzi (aproape) toate lucrurile pozitive cu care te identificai și, ca-ntr-o centrifugă, să se dezlipească de tine, rând pe rând, straturi ale egoului.
Nici eu nu scap, nici prietenii sau familia, „suntem în aceeași oală și fierbem înăbușit”, ca să-l citez pe Steinhardt, cu plastica lui exprimare.
Poate că unul dintre rosturile pe care le avem pe pământ, în scurta noastră trecere pe aici, este să deprindem căile vieții și să gustăm trezirea sufletului.
Nu poți învăța căile sufletului așa cum înveți integrale, pentru că viața are lecții diferite și un parcurs distinct pentru fiecare dintre noi, dar putem să ne educăm capacitatea de a învăța din durerea inevitabilă sau ne putem victimiza. (Lecțiile pe care nu le învățăm, le predăm mai departe, ca o ștafetă păguboasă, următoarei generații pentru a le integra, așa că mai bine „lucrăm” bucata noastră de responsabilitate emoțională, spirituală, relațională și lăsăm în spate o moștenire mai bună, pe cât posibil. Paranteză închisă.)
Durerea care doar te doare şi durerea care te schimbă… primul tip de durere te face victimǎ, te aruncǎ în acuzații și plângeri de milǎ: de ce ție, de ce acum, de ce. Durerea care doar doare este superficială, nu schimbă ceva în tine, eventual este o pistă pentru căutare de atenție din exterior.
Durerea care te schimbă este cea care te trezește în miezul ființei, îți electrocutează conştiința și o expandează la un alt nivel de înțelegere a vieții.
Din experiența în lucrul cu oamenii, cele mai adânci dureri sunt cele despre care nu vorbim aproape niciodată, dar ne sculptează chipul, relațiile, alegerile.
Durerea care schimbă te conduce dezbrăcat de ego în nucleul personalității și îți trezește sufletul – de acolo se nasc marile întrebări, căutări și frământări, unele care durează mii de zile.
Au fost teme în parcursul meu care au necesitat o căutare activă mai mult de zece ani: abandon, reîntoarcere la necunoscute și abia acum intuiesc ce presupune seriozitatea unui proces de sondare a unor realități interioare, ce resurse complexe sunt necesare, ce cultură generală, vastitate a conceptelor și efort.
În primul rând, durerea care m-a trezit, m-a smerit profund, mi-a arătat fără echivoc locul meu într-un Univers căruia nu-i cunoaștem capetele și încă nu-l avem cartografiat complet, în ciuda instrumentelor performante care încearcă aceasta.
Slǎbiciunile mi-au oferit smerenia de a înțelege bǎtǎliile pierdute ale altora.
Defectele m-au învǎțat sǎ accept la mine şi la oamenii din jurul meu ce nu pot schimba.
Limitele personale mi-au oferit darul îngǎduiței fațǎ de semenul meu.
Durerile mi-au dat sensibilitatea de a surprinde cu empatie durerile altora.
Durerea care schimbă mi-a arătat cu claritate realitatea următoare: cunoaşterea mea este o picătură într-un ocean de necunoaștere, necunoscute și nebănuite. Mai citește o dată această propoziție, te rog.
Cu toții suntem vulnerabili, mai vulnerabili decât ne închipuim, mai preocupați de aparențe decât ar fi cazul, prea ocupați cu măști sociale în loc să ne privim frontal slăbiciunile, defectele, limitele și de aici să vedem cu claritate că suntem în aceeași barcă a (supra)viețuirii, dar putem fi mai conștienți de tiparele care ne conduc în dinamici distructive sau abuzive.
Conștiența este ingredientul numărul unu în durerea care te trezește. Și de la pasul conștienței, treptat, ne putem rupe de ele, pentru că noi moștenim și iubirea, și resursele, și binele. Moștenim și capacitatea de schimbare, adaptabilitatea.
Însă aceste procese lungi nu se nasc în minți superficiale, obișnuite cu victimizarea și blamarea altora, ci cu asumarea responsabilității radicale.
Este greu? Da!
Este plin de sens? Da, este plin de sens și de bogăție interioară!
Binecuvântate fie întrebările pentru că acestea ne fac să chestionăm certitudinile în care băltim de când ne-am aflat.
„Cine vrea să se mântuiască, cu întrebarea să călătorească”, spune o vorbă din popor.
Binecuvântate fie întrebările pentru că ele scormonesc minciunile din noi!
Binecuvântate fie întrebările pentru că ele ne conduc spre răspunsuri necesare înțelegerii.
Durerea m-a învățat că nu contează ce pierd în exterior, autenticitatea și trezirea sufletului sunt urmele unice ale trecerii mele pe Pământ. Autenticitatea care cuprinde darurile pe care Dumnezeu Mi Le-a dat și trezirea sufletului, un proces coordonat tot de El, dar inițiat de conștiință, care este aliatul lui Dumnezeu în ființa umană.
Eu și cu tine… suntem un fir de praf de miracol pe care Dumnezeu L-a selectat după un algoritm necunoscut nouă să fim aici, pe Pământ, în acest loc, timp și spațiu – ce putem face cu darul vieții este ca din bubele, mucegaiurile şi noroiul existenței, din inevitabila durere a condiției umane, să iscăm frumuseți și prețuri noi ale trezirii conștiinței și sufletului.
Discover more from Rotaru Alina-Anamaria
Subscribe to get the latest posts sent to your email.